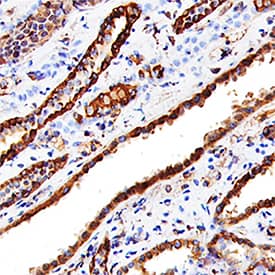
Cathepsin L antibody in Human Kidney by Immunohistochemistry (IHC-P).

Human Cathepsin L Antibody
R&D Systems, part of Bio-Techne | Catalog # AF952


Key Product Details
Validated by
Species Reactivity
Validated:
Cited:
Applications
Validated:
Cited:
Label
Antibody Source
Product Specifications
Immunogen
Glu113-Val333
Accession # P07711
Specificity
Clonality
Host
Isotype
Scientific Data Images for Human Cathepsin L Antibody
Detection of Recombinant Human Cathepsin L by Western Blot.
Western blot shows 10 ng of Recombinant Human Cathepsin L (952-CY), Recombinant Mouse Cathepsin L (1515-CY), Recombinant Human Cathepsin V (1080-CY), Recombinant Human Cathepsin K, Recombinant Human Cathepsin S (1183-CY), Recombinant Human Cathepsin H (7516-CY), and Recombinant Human Cathepsin F. PVDF Membrane was probed with 0.1 µg/mL of Goat Anti-Human Cathepsin L Antigen Affinity-purified Polyclonal Antibody (Catalog # AF952) followed by HRP-conjugated Anti-Goat IgG Secondary Antibody (HAF109). A specific band was detected for Cathepsin L at approximately 35 kDa (as indicated). This experiment was conducted under reducing conditions and using Immunoblot Buffer Group 3.Cathepsin L in Human Kidney.
Cathepsin L was detected in immersion fixed paraffin-embedded sections of human kidney using Goat Anti-Human Cathepsin L Antigen Affinity-purified Polyclonal Antibody (Catalog # AF952) at 15 µg/mL overnight at 4 °C. Tissue was stained using the Anti-Goat HRP-DAB Cell & Tissue Staining Kit (brown; CTS008) and counterstained with hematoxylin (blue). Specific staining was localized to convoluted tubules. View our protocol for Chromogenic IHC Staining of Paraffin-embedded Tissue Sections.Detection of Human Cathepsin L by Western Blot
Cathepsins are reduced in GNPTAB- knockout cells, but restored upon GNPTAB reconstitution. a Immunoblotting of lysates from parental, knockout and reconstituted cells for CatB and CatL. The migration of a 30 kDa molecular mass marker is shown to the right. b CatB activity in lysates from parental HAP1, or knockout GNPTAB- or NPC1-cells. Cells were treated with cathepsin B inhibitor (Bi), cathepsin L inhibitor (Li), at 10 or 1 µM, or DMSO vehicle control for 1 h at 37 °C, before lysis and incubation with fluorescent CatB peptide substrate. After 1 h incubation at room temperature, fluorescence was measured. Data represent the mean ± s.d. of three technical replicates. A representative of three independent experiments is shown. c CatB activity in lysates from reconstituted cells. Lysates from transduced HAP1 or GNPTAB− cells were generated and tested for CatB activity, as for panel b. Data represent the mean ± s.d. of three technical replicates. A representative of two independent experiments is shown. For both panels b and c, statistical analysis was performed with a two-tailed Student’s t-test with significance shown as **** P ≤ 0.0001. Image collected and cropped by CiteAb from the following open publication (https://pubmed.ncbi.nlm.nih.gov/30655525), licensed under a CC-BY license. Not internally tested by R&D Systems.Applications for Human Cathepsin L Antibody
Immunohistochemistry
Sample: Immersion fixed paraffin-embedded sections of human kidney
Immunoprecipitation
Sample: Conditioned cell culture medium spiked with Recombinant Human Cathepsin L (Catalog # 952-CY), see our available Western blot detection antibodies
Western Blot
Sample: Recombinant Human Cathepsin L (Catalog # 952-CY)
Human Cathepsin L Sandwich Immunoassay
Formulation, Preparation, and Storage
Purification
Reconstitution
Formulation
Shipping
Stability & Storage
- 12 months from date of receipt, -20 to -70 °C as supplied.
- 1 month, 2 to 8 °C under sterile conditions after reconstitution.
- 6 months, -20 to -70 °C under sterile conditions after reconstitution.
Background: Cathepsin L
Cathepsin L is a lysosomal cysteine protease expressed in most eukaryotic cells. Cathepsin L is known to hydrolyze a number of proteins, including the proform of urokinase-type plasminogen activator, which is activated by Cathepsin L cleavage (1). Cathepsin L has also been shown to proteolytically inactivate alpha1-antitrypsin and secretory leucoprotease inhibitor, two major protease inhibitors of the respiratory tract (2). These observations, combined with the demonstration of increased Cathepsin L activity in the epithelial lining fluid of the lungs of emphysema patients, have led to the suggestion that the enzyme may be involved in the progression of this disease. Cathepsin L has also been identified as a major excreted protein of transformed fibroblasts, indicating the enzyme could be involved in malignant tumor growth (3). Human Cathepsin L activity is greatest under mildly acidic conditions, from pH 4.5‑6.5. The stability of the enzyme decreases at higher pH values.
References
- Goretzki, L. et al. (1992) FEBS Lett. 297:112.
- Taggart, C.C. et al. (2001) J. Biol. Chem. 276:33345.
- Gottesman, M.M. and F. Cabral (1981) Biochemistry 20:1659.
Alternate Names
Gene Symbol
UniProt
Additional Cathepsin L Products
Product Documents for Human Cathepsin L Antibody
Product Specific Notices for Human Cathepsin L Antibody
For research use only